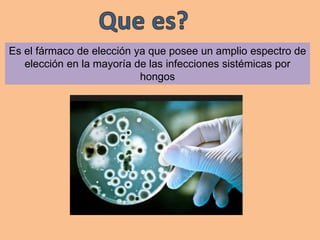
Es el fármaco de elección ya que posee un amplio espectro de
elección en la mayoría de las infecciones sistémicas por
hongos

El documento habla sobre los aminoglucósidos, un grupo de antibióticos usados para tratar infecciones bacterianas. Se detalla su mecanismo de acción, espectro, fases de penetración celular, presentaciones y dosis recomendadas para diferentes infecciones. También describe los principales aminoglucósidos (gentamicina, tobramicina, amikacina, etc.), sus indicaciones y efectos adversos como la toxicidad renal y auditiva.